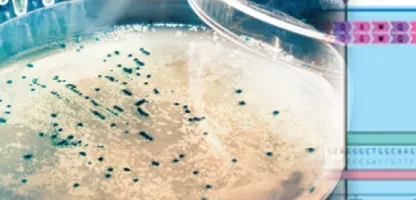
biology petri dish with blue design background

Drug Discovery
From idea to IND, for every modality. Bring your disciplines together, from small molecules to large modalities. Accelerate your drug discovery with Signals One™ by eliminating your data silos and empowering your users.

Leading Drug Discovery Organizations Choose Revvity Signals
Scientific software that helps you save time and focus on your science.
80%
Reduced expenses
17,000
Staff hours saved
50%
Storage fee cost savings
Scientific products to support your drug discovery
Resources
Keep Up With The Latest With Guides, Research, And Insights.

Drug Discovery FAQs
Ready to take the next step?
Start Your Trial
Sign up for a free, no-commitment trial of Signals ChemDraw, Signals Notebook, Spotfire®, or Lead Discovery Premium today.
Explore New AI Features
Discover how AI-powered design is converging with experimental science with Signals Xynthetica™.
Get in Touch
We’re here to help with any questions about our products, pricing, implementation or beyond.




































